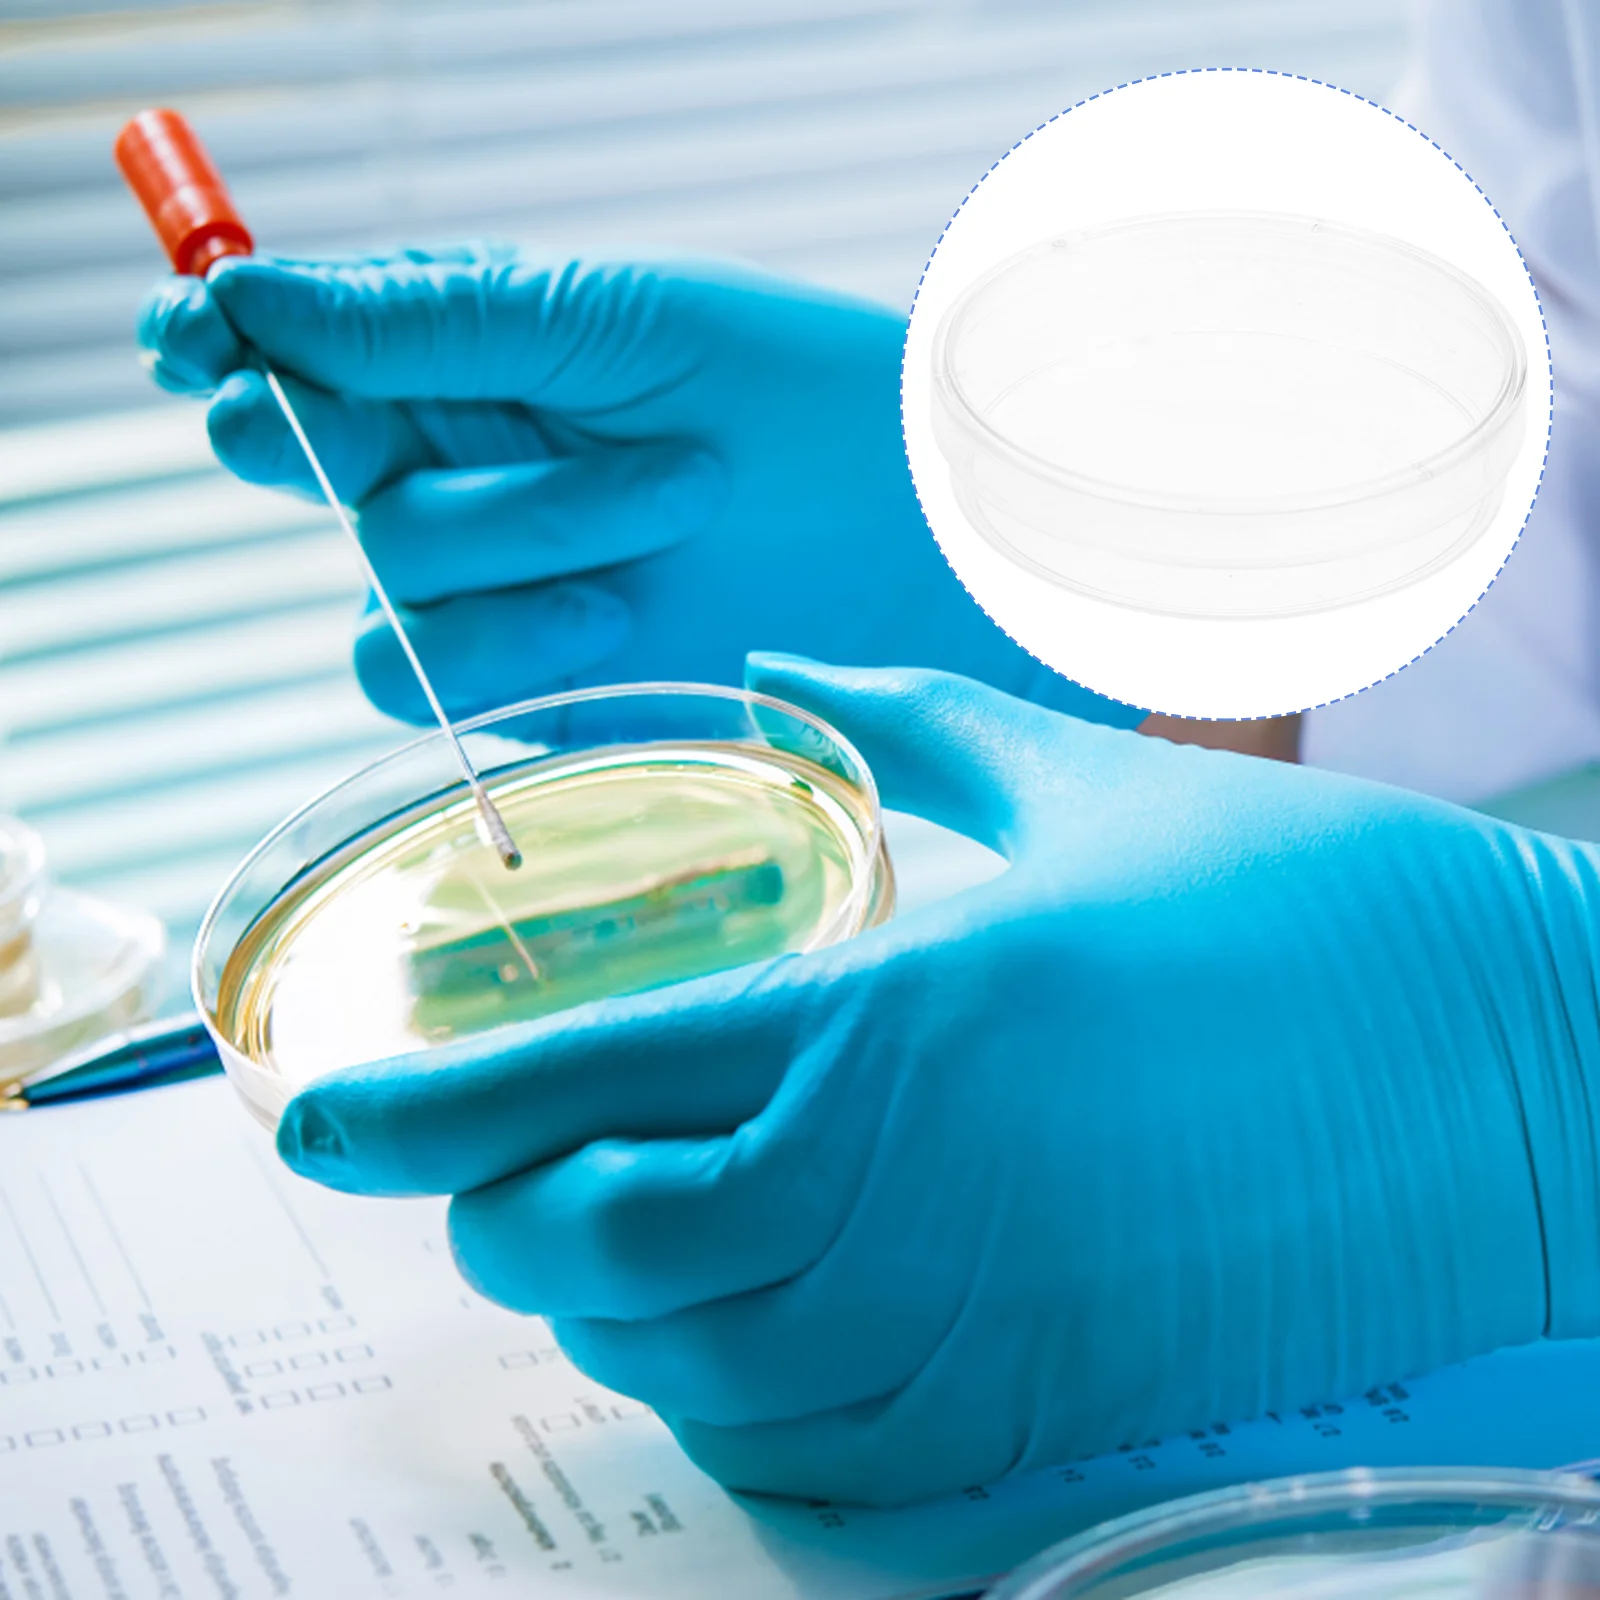

Варочная панель электрическая Korting HK 32033 B черный





Korting
артикул: 591408
СОГЛАСНО НАШИМ ДАННЫМ, ЭТОТ ПРОДУКТ СЕЙЧАС НЕ ДОСТУПЕН
16,990.00 руб.
Доставка из: Россия
Описание
Сенсорное управление TOUCH CONTROL, Вам достаточно одного прикосновения для включения зон нагрева, выбора уровня мощности или зоны нагрева. Ошибка при включении абсолютно невозможна благодаря световой индикации и продуманному расположению сенсорных кнопок., , Hilight, Зоны нагрева Korting оборудованы современными нагревательными элементами Hilight, которые отличаются высокой скоростью нагрева, энергоэффективностью и надежностью., , Таймер, Установите временной отрезок для приготовления блюда и занимайтесь своими делами, в нужное время Таймер сам выключит зону нагрева или оповестит Вас об окончании временного промежутка., , Двойная круглая зона расширения, Korting дарит Вам удобство использования двухконтурной зоны нагрева. Вы можете по выбору включать площадь нагрева большего или меньшего диаметра, подходящую под большую сковороду или маленькую кастрюлю. Площадь зоны нагрева изменяется при легком нажатии сенсорной кнопки или простым поворотом регулятора., , Автоматическое отключение, Защитное устройство самоотключения в варочных поверхностях Korting выключает конфорки или всю варочную панель через определенное время, если с вашей стороны не поступает никаких других команд., , Индикация остаточного тепла, Световой индикатор в варочных поверхностях Korting горит, пока температура соответствующего нагревательного поля не понизится до 60 С. Это можно также использовать для подогрева блюд при уже выключенной плите, что позволяет экономить электроэнергию., , Функция "Защита детей", Korting подумал о безопасности Ваших малышей! Функция "защита детей" заблокирует всю панель и маленький непоседа не сможет включить поверхность.
Характеристики
Color: | черный |
Бренд: | Korting |
Всего конфорок: | 2 |
Высота: | 6 |
Газ-контроль конфорок: | нет |
Глубина: | 51 |
Глубина встраивания: | 49 см |
Индикатор остаточного тепла: | есть |
Конфорок индукционных: | 2 |
Максимальная потребляемая мощность: | 3,65 |
Материал панели: | стеклокерамика |
Модель: | HK 32033 B |
Переключатели: | сенсорные |
Распознавание размера посуды: | нет |
Распознование наличие посуды: | нет |
Расположение панели управления: | спереди |
Таймер конфорок: | есть |
Тип: | электрическая |
Установка: | независимая |
Ширина: | 29 |
Ширина встраивания: | 27 см |
Электроподжиг: | нет |
График изменения цены & курс обмена валют
Пользователи также просматривали

21,358.43 руб.
Mindray WATO EX20 WATO EX30 WATO EX35 натриевые компоненты емкости для Лайма для аппарата для анестезии
aliexpress.ru
134,393.44 руб.
Outdoor Patio Porch Egg Swing Chair Hanging leisure chair Equipped with backrest cushion 40"D x 43.5"W x 77"H
aliexpress.ru
368.77 руб.
Тестовая ручка для автомобиля, 6-24 В, с удлинителем провода, тестеры напряжения для автомобильных мотоциклов, для задних фонарей, сигналов поворота
aliexpress.ru
469.57 руб.
Карбюратор для газонокосилки Briggs & Stratton 795477 заменяет 498811 795469 794147 699660
aliexpress.ru
757.21 руб.
Однотонные конверты, пустые конверты для упаковки, конверты из крафт-бумаги, конверты из переработанной бумаги, коричневый пакет из крафт-бумаги бумажная сумка
aliexpress.ru
203.23 руб.
Newborn Lace Floral Pacifier Chain Nipple Holder Leash Strap Soother Nursing Teether Clip Dropship
aliexpress.ru
901.44 руб.
Роскошные темпераментные модные женские часы с квадратным циферблатом и бриллиантами изысканные Кварцевые водонепроницаемые часы в минималистском стиле
aliexpress.ru
14,300.96 руб.
Ashley Paxberry Boho Chic Panel Adjustable Headboard ONLY, Full, Whitewash
aliexpress.com
1,157.12 руб.
Cartoon Rabbit Keycaps The Rabbit Cute Three-dimensional Personalized Key Caps Mechanical Keyboard Caps Rabbit keycaps Gifts
aliexpress.com
5,193.12 руб.
Новинка, звёздный план, компактный боец MOC, космические строительные блоки, сборные кирпичи, модель «сделай сам», подарок на день рождения для детей
aliexpress.ru
4,897.29 руб.
Многофункциональный Многоязычный умный переводчик-ручка словарь перевод электронный язык ABS
aliexpress.ru
3,503.33 руб.
61357394649 блок управления задней дверью для BMW F25 F26 F07 F01 F10 X3 X4 7394649 Функциональный модуль заднего багажника
aliexpress.ru
3,727.05 руб.
Кнопка переключения рулевого колеса автомобиля, 5 клавиш, для Mercedes Benz W164 W251 W245 ML GL B R CLass 2006-2009 Advance Ver
aliexpress.ru
2,982.95 руб.
Роскошное ожерелье 2023, оригинальный дизайн, высококачественное Свадебное Сердце, градиентный цвет, Бриллиантовая подвеска, ювелирные изделия, жемчужные Подарки для пар
aliexpress.ru
2,306.87 руб.
Школьный портфель XZAN для детей-подростков, большой водонепроницаемый рюкзак с принтом для учеников начальной школы
aliexpress.ru
3,262.40 руб.
Женская зимняя куртка с капюшоном и меховым воротником, длинная плюшевая куртка из искусственного меха, черная пушистая куртка, новинка 2023, элегантная верхняя одежда
aliexpress.ru
336.81 руб.
Женская спортивная одежда grast element в стиле ретро, осенний Новый женский свитер с капюшоном и карманами, удобный женский топ большого размера
aliexpress.ru
594.13 руб.
2 шт., водонепроницаемые Нескользящие бумажные папки для документов с защелкой
aliexpress.ru
222.90 руб.
10 шт. блюдо для культуры, лабораторный держатель для культуры, держатель для химической культуры, блюдо для культуры, круглое блюдо
aliexpress.ru
550.70 руб.
Автомобильный солнцезащитный козырек с большим муравьем, солнцезащитный козырек на лобовое стекло, дизайнерские солнцезащитные козыреки с масляными муравьями для защиты автомобиля от лучшего УФ-луча, солнцезащитный козырек
aliexpress.ru
2,342.11 руб.
designer cases handbags toiletry travel makeup pouch zippy wash bag women purses 28cm lb137 cosmetic bags storage bag
dhgate.com
269.00 руб.
Чехол на Motorola Moto G7 Power "Собачка в шапке лягушки", Коричневый;желтый;голубой, 241350-1
goods.ru
269.00 руб.
Чехол на Samsung Galaxy M01 "Девушка в черном купальнике", Зеленый;бежевый;черный, 2101150-6
goods.ru
3,359.10 руб.
BWS 23 inch Concert Gift Ukulele 4 AQUILA Strings Hawaiian mini Guitar for Uku Acoustic Guitar Ukelele cartoon giraffe UK2318
aliexpress.com
6,797.69 руб.
3 цвета, автомобильный ускоритель, автоматический электронный контроллер дроссельной заслонки, автомобильная педаль, бустер, генератор акс...
aliexpress.ru
246.67 руб.
Щетка для чистки обуви, многофункциональный белый прибор для чистки кроссовок
aliexpress.ru
172.91 руб.
Кожа ремесло из чистой латуни кожаный край украшения инструмент идеально подходит для DIY Кожа ремесло любовника 3 паза
aliexpress.ru
576.92 руб.
Summer Women Solid Colour O-Neck Sleeveless Casual Tank Dress Straight Mini Party Dress Elegant Dresses
aliexpress.com
7,096.80 руб.
Hand Rivet Nut Thread Setter Riveter Tool Set Heavy Duty M3/M4/M5/M6/M8/M10 Professional with 100 Nuts 7 Mandrels Toolbox
aliexpress.com
490.88 руб.
New Spot wholesale wrist guard wrist sprain fracture tenosynovitis thumb steel bar support hand protector can be customized gym
aliexpress.com
3,157.50 руб.
Ionizer Air Purifier Negative Ionizer Timing Quiet Activated Carbon Air Purifier for Home Office Remove Formaldehyde Smoke EU Pl
aliexpress.com